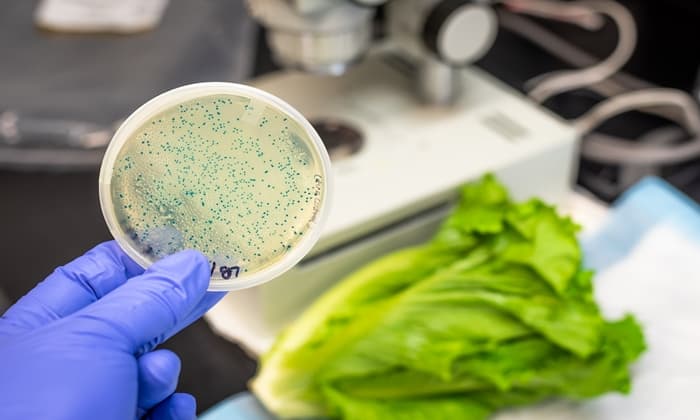
เชื้อจุลินทรีย์ในอาหาร ที่พบบ่อย และต้องระวังให้ดี หากคุณไม่อยากมีปัญหาสุขภาพ

อาหารที่ดีต้องช่วยส่งเสริมสุขภาพ กินแล้วร่างกายเจริญเติบโต แข็งแรงขึ้น แต่บ่อยครั้งที่คนเราป่วยจากการกินอาหาร เช่น ท้องร่วง ท้องเสีย อาหารเป็นพิษ ซึ่งปัญหาสุขภาพเหล่านี้เป็นผลจากการจากกินอาหารที่ปนเปื้อนเชื้อจุลินทรีย์ ไม่ว่าจะเป็นแบคทีเรีย ไวรัส หรือปรสิตต่างๆ แต่… เชื้อจุลินทรีย์ในอาหาร ที่พบได้บ่อยจะมีอะไรบ้าง แล้วเราจะป้องกันตัวเองจากการติดเชื้อเหล่านั้นได้อย่างไร Hello คุณหมอ มีคำตอบมาให้คุณแล้ว
เชื้อจุลินทรีย์ในอาหาร ที่พบบ่อย และต้องระวังให้ดี หากคุณไม่อยากมีปัญหาสุขภาพ

เชื้อจุลินทรีย์ในอาหาร ที่พบบ่อย
อีโคไล
เชื้ออีโคไล (Escherichia coli หรือ E.coli) เป็นแบคทีเรียที่อาศัยอยู่ในลำไส้ของคนและสัตว์ โดยเฉพาะสัตว์เลี้ยงลูกด้วยนม นก และสัตว์เลี้ยงคลาน พูดง่ายๆ ก็คือ สัตว์หลายชนิดที่คนเรานิยมนำมาบริโภค ไม่ว่าจะเป็นวัว หมู ไก่ แกะ แพะ รวมถึงผลิตภัณฑ์จากสัตว์ดังกล่าว เช่น นมวัวดิบ หรือแม้กระทั่งน้ำเปล่า ก็เสี่ยงปนเปื้อนเชื้ออีโคไลได้ทั้งสิ้น
หากติดเชื้ออีโคไล จะมีอาการ ได้แก่ ท้องเสียรุนแรง ปวดท้อง อาเจียน เป็นเวลา 5-10 วัน และถึงแม้เชื้ออีโคไลส่วนใหญ่จะไม่เป็นอันตราย แต่บางสายพันธุ์ก็อาจก่อให้เกิดปัญหาสุขภาพร้ายแรงได้ เช่น อีโคไล ซีโรไทป์ O157:H7 ที่สามารถทำให้ถ่ายเป็นเลือด ไตวาย หรือถึงขั้นเสียชีวิตได้
ลิสเตอเรีย
ลิสเตอเรีย (Listeria monocytogenes หรือ Listeria) เป็นแบคทีเรียที่พบได้ทั่วไปในดิน น้ำ รวมถึงอาหารอีกหลายชนิด ไม่ว่าจะเป็นเนื้อสัตว์ดิบ ผักผลไม้ดิบ น้ำนมดิบ ผลิตภัณฑ์จากน้ำนมดิบ เนื้อสัตว์แปรรูป (เช่น ไส้กรอก แฮม) ชีสประเภทซอฟต์ชีส (เช่น มอสซาเรลล่าชีส ริคอตต้าชีส) รวมถึงอาหารทะเลรมควันแช่เย็น
อาการของการติดเชื้อลิสเตอเรีย ได้แก่ มีไข้ หนาวสั่น ปวดศีรษะ ท้องไส้ปั่นป่วน อาเจียน โดยบางคนอาจมีอาการรุนแรง หรือเป็นอันตรายถึงชีวิตได้ด้วย
แคมไพโลแบคเตอร์
เชื้อแคมไพโลแบคเตอร์ (Campylobacter) เป็นเชื้อจุลินทรีย์ในอาหารอีกชนิดที่พบได้ในวัด หมู แกะ และสัตว์ปีก เช่น ไก่ ไก่งวด
อาการของการติดเชื้อแคมไพโลแบคเตอร์มักปรากฏให้เห็นภายใน 2-5 วันหลังได้รับเชื้อ โดยอาการที่พบได้ทั่วไป ได้แก่ ปวดมวนท้อง มีไข้ ท้องเสีย และบางรายอาจถึงขั้นถ่ายเป็นเลือด หรือมีอาการคลื่นไส้ อาเจียนร่วมด้วย โดยปกติแล้วจะมีอาการประมาณ 1 สัปดาห์
ท็อกโซพลาสมา กอนดิ
ท็อกโซพลาสมา กอนดิ (Toxoplasma gondii ; T.gondii) เป็นปรสิตที่พบได้ในสัตว์เลี้ยง เช่น แมว สุนัข และสัตว์เลือดอุ่น โดยจะเจริญเติบโตในผนังลำไส้ของสัตว์ แต่สามารถสืบพันธุ์ได้เฉพาะในสัตว์ตระกูลแมวเท่านั้น หากคุณสัมผัสกับอุจจาระแมว ก็อาจติดเชื้อได้ นอกจากนี้ การสัมผัสหรือกินเนื้อสัตว์ดิบที่ปนเปื้อน โดยเฉพาะแบบไม่ปรุงสุก เช่น ลาบดิบ สเต็ก รวมถึงการบริโภคน้ำดื่มที่ปนเปื้อน ก็สามารถทำให้คุณได้รับปรสิตชนิดนี้ได้เช่นกัน
โดยทั่วไปแล้ว ผู้ที่ได้รับปรสิตชนิดนี้จะไม่เกิดอาการเจ็บป่วยใดๆ แต่ในบางกรณีก็อาจทำให้เป็นโรคท็อกโซพลาสโมซิส (Toxoplasmosis) ที่มีอาการคล้ายไข้หวัด เช่น ปวดศีรษะ มีไข้ ปวดกล้ามเนื้อ หากเป็นคุณแม่ที่ตั้งครรภ์หรือคนที่ภูมิคุ้มกันอ่อนแอ ก็อาจทำให้สมอง ตา และอวัยวะอื่นๆ ถูกทำลายได้
ซาลโมเนลลา
ซาลโมเนลลา (Salmonella) เป็นเชื้อแบคทีเรียที่พบได้บ่อยในเนื้อสัตว์ดิบ เช่น เนื้อวัว เนื้อไก่ รวมถึงไข่ไก่ และบางครั้งอาจพบในผักและผลไม้ได้ด้วย
การติดเชื้อซาลโมเนลลาจะทำให้เกิดอาการ มีไข้ ท้องเสีย ปวดท้อง ปวดศีรษะ ประมาณ 4-7 วัน โดยส่วนใหญ่อาการจะหายได้เองโดยไม่ต้องเข้ารับการรักษา แต่หากเป็นผู้ป่วยเรื้อรัง เด็กหรือผู้สูงอายุ ถ้าไม่รักษา อาจรุนแรงถึงขั้นเสียชีวิตได้
โนโรไวรัส
โนโรไวรัส (Norovirus) เป็นเชื้อไวรัสที่ก่อให้เกิดโรคท้องเสีย รวมถึงโรคกระเพาะและลำไส้อักเสบ ซึ่งสามารถพบได้ในน้ำและอาหาร โดยเฉพาะหอยที่ปรุงไม่สุก ผักผลไม้ที่ล้างไม่สะอาด นอกจากนี้ การสัมผัสกับสิ่งของที่ปนเปื้อน หรือการสัมผัสกับผู้ป่วยโดยตรง ก็สามารถทำให้คุณติดเชื้อโนโรไวรัสได้เช่นกัน
อาการของการติดเชื้อโนโรไวรัสจะปรากฏให้เห็นภายใน 12-48 ชั่วโมงหลังได้รับเชื้อ โดยอาการทั่วไปได้แก่ ท้องเสีย คลื่นไส้ อาเจียน ปวดท้อง และอาจมีไข้ ปวดศีรษะ ปวดกล้ามเนื้อด้วย
ใครที่ยิ่งต้องระวังให้มาก
การติดเชื้อจุลินทรีย์ในอาหาร สามารถก่อให้เกิดโรคได้มากมาย ซึ่งก่อให้เกิดอาการได้ตั้งแต่ อาการเบาๆ เช่น คลื่นไส้ อาเจียน ปวดท้อง ท้องเสีย ไปจนถึงอาการรุนแรงที่อาจเป็นอันตรายถึงชีวิต และยิ่งหากคุณหรือคนที่คุณรักเข้าข่ายต่อไปนี้ ก็ยิ่งต้องระวังการติดเชื้อจุลินทรีย์ในอาหารให้ดี
- ผู้สูงอายุ โดยเฉพาะที่อายุมากกว่า 65 ปีขึ้นไป เนื่องจากระบบภูมิคุ้มกันและอวัยวะต่างๆ ในร่างกายเริ่มเสื่อมถอย ทำให้ไม่สามารถต่อสู้กับเชื้อจุลินทรีย์ได้ดีเท่าที่ควร
- เด็ก โดยเฉพาะที่อายุน้อยกว่า 5 ปี เนื่องจากระบบภูมิคุ้มกันยังไม่เจริญเติบโตเต็มที่ ร่างกายจึงรับมือกับเชื้อจุลินทรีย์ และเชื้อโรคได้ไม่ดีนัก
- ผู้ที่ภูมิคุ้มกันอ่อนแอ เช่น ผู้ป่วยโรคเบาหวาน โรคตับ โรคไต โรคพิษสุรา (alcoholism) ผู้ติดเชื้อเอชไอวี โดยเฉพาะในระยะเอดส์ รวมถึงผู้ที่เข้ารับการรักษาด้วยเคมีบำบัด หรือรังสีรักษา ก็ต้องระวังเชื้อจุลินทรีย์ต่างๆ เอาไว้ให้ดีเช่นกัน
- หญิงตั้งครรภ์ ก็เสี่ยงติดเชื้อจุลินทรีย์ในอาหารได้มากเช่นกัน โดยเฉพาะเชื้อลิสเตอเรีย โดยผู้เชี่ยวชาญเผยว่า หญิงตั้งครรภ์มีโอกาสติดเชื้อจุลินทรีย์ชนิดนี้ได้มากกว่าปกติถึง 10 เท่า
วิธีป้องกันเบื้องต้น
คุณสามารถป้องกันตัวเองจากเชื้อจุลินทรีย์ในอาหารได้ง่ายๆ ด้วยวิธีเหล่านี้
- ซื้อวัตถุดิบประกอบอาหารจากร้านที่สะอาด ปลอดภัย และเชื่อถือได้
- เนื้อสัตว์ไม่ควรเก็บไว้นานเกิน 3-5 วัน หากเป็นเนื้อสัตว์แปรรูป เช่น ไส้กรอก แฮม หรือชีส ไม่ควรเก็บเกิน 2 สัปดาห์
- ล้างมือให้สะอาดทั้งก่อนและหลังปรุงอาหาร รวมถึงหลังจากสัมผัสกับเนื้อสัตว์ดิบด้วย
- ปรุงเนื้อสัตว์ที่ความร้อนอย่างน้อย 70 องศาเซลเซียส และรับประทานเนื้อสัตว์ที่ปรุงสุกแล้วเท่านั้น
- ล้างผักผลไม้ให้สะอาดก่อนนำไปประกอบอาหาร โดยเฉพาะหากจะกินสด ยิ่งต้องล้างให้ดี
- ไม่บริโภคน้ำผลไม้หรือนมที่ไม่ผ่านการพาสเจอร์ไรส์
- ล้างทำความสะอาดอ่างล้างจาน เคาน์เตอร์ทำครัว และอุปกรณ์ทำครัว เช่น มีด เขียง ทันทีหลังทำอาหารเสร็จ
- ทำความสะอาดห้องครัว ตู้เย็น หรือตู้แช่เป็นประจำ โดยเฉพาะเมื่อมีน้ำจากเนื้อสัตว์ไหลเปรอะเปื้อน
Hello Health Group ไม่ได้ให้คำปรึกษาด้านการแพทย์ การวินิจฉัยโรค หรือการรักษาโรคแต่อย่างใด
หมายเหตุ
Hello Health Group ไม่ได้ให้คำแนะนำด้านการแพทย์ การวินิจฉัยโรค หรือการรักษาโรคแต่อย่างใด
Top 7 Germs in Food that Make You Sick. https://www.livescience.com/36328-top-food-borne-illness-germs-sick.html. Accessed January 29, 2020
Foodborne Germs and Illnesses. https://www.cdc.gov/foodsafety/foodborne-germs.html. Accessed January 29, 2020
Bacteria and Viruses. https://www.foodsafety.gov/food-poisoning/bacteria-and-viruses. Accessed January 29, 2020
What Are Germs?. https://kidshealth.org/en/kids/germs.html. Accessed January 29, 2020
10 Types of Harmful Bacteria that Spread & Develop in your Restaurant Kitchen. https://www.venners.com/10-types-of-harmful-bacteria-in-your-restaurant-kitchen/. Accessed January 29, 2020
Food Safety: People With a Higher Risk. https://www.cdc.gov/foodsafety/people-at-risk-food-poisoning.html. Accessed January 29, 2020
เวอร์ชันปัจจุบัน
11/05/2020
เขียนโดย เนตรนภา ปะวะคัง
ตรวจสอบความถูกต้องของข้อมูลโดย ทีม Hello คุณหมอ
อัปเดตโดย: Sukollaban Khamfan
ตรวจสอบความถูกต้องของข้อมูลโดย
ทีม Hello คุณหมอ